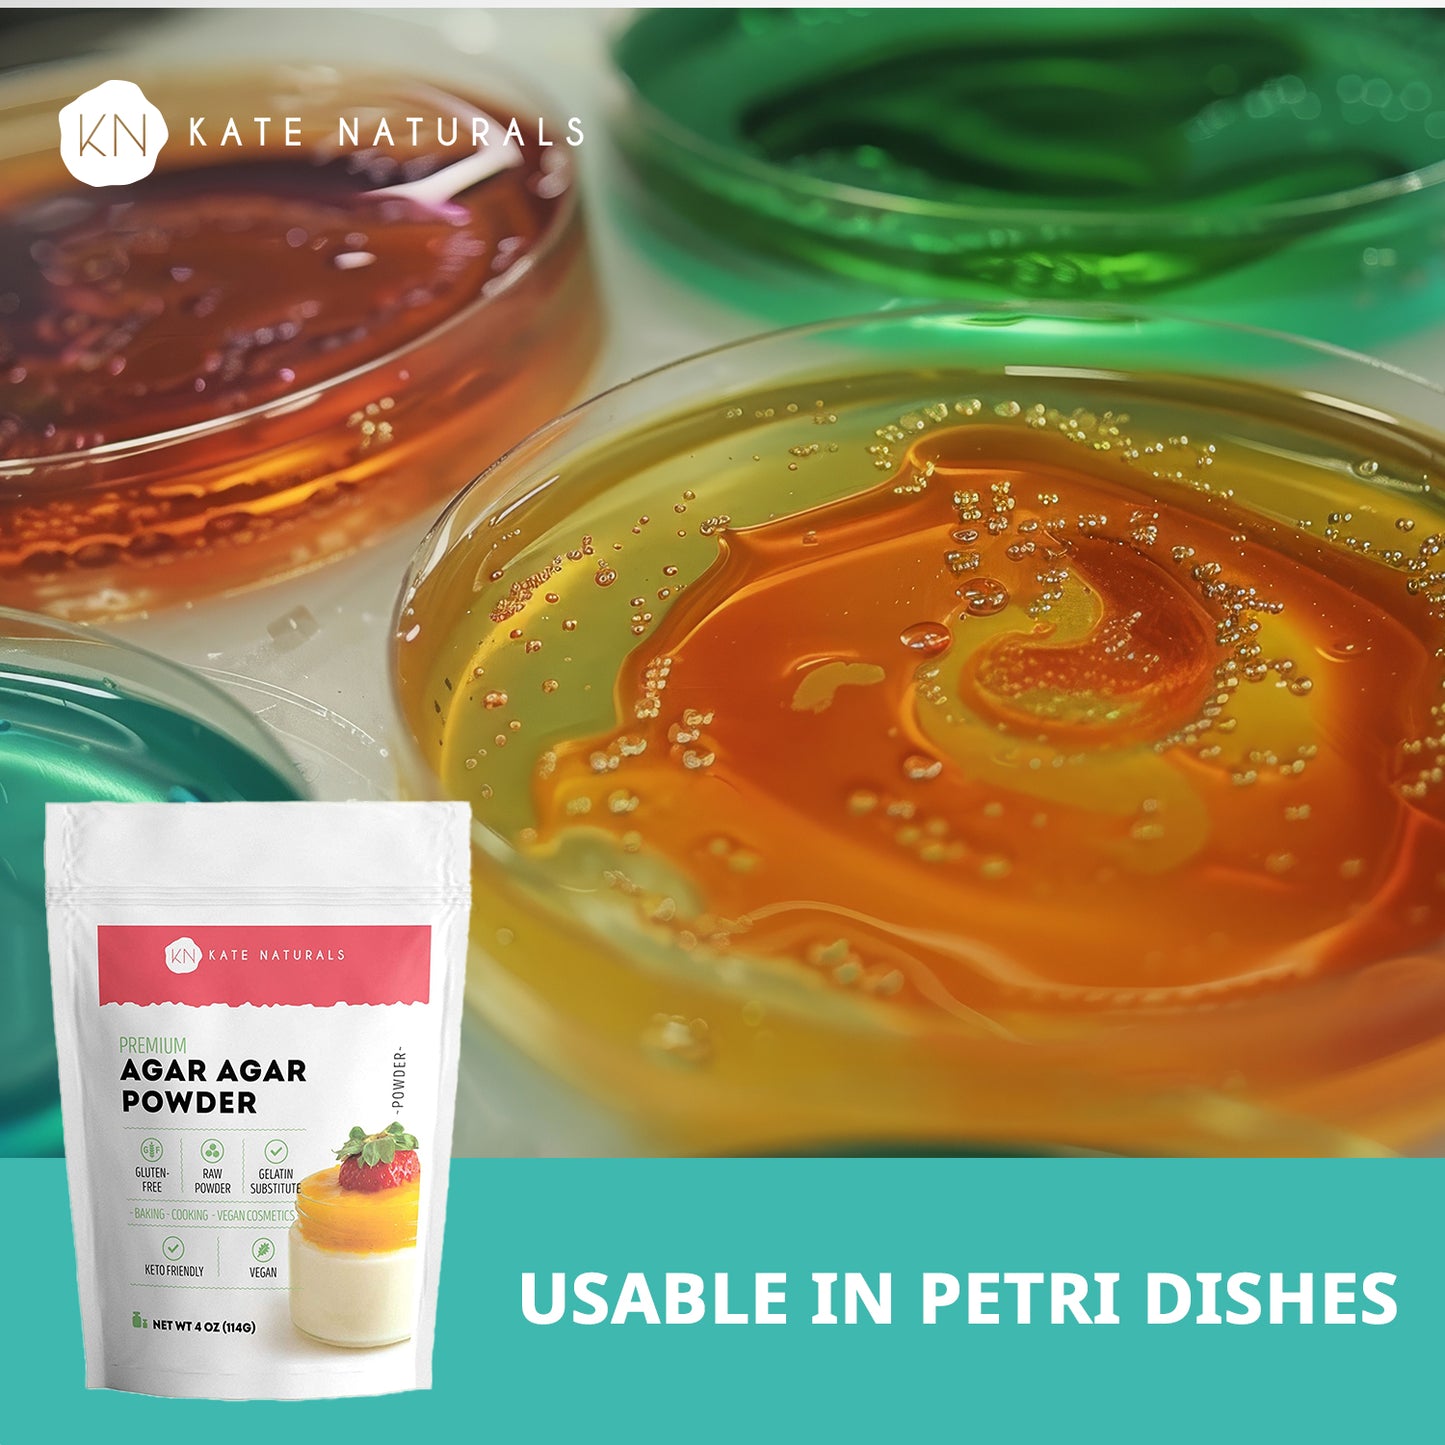
Agar Agar Powder
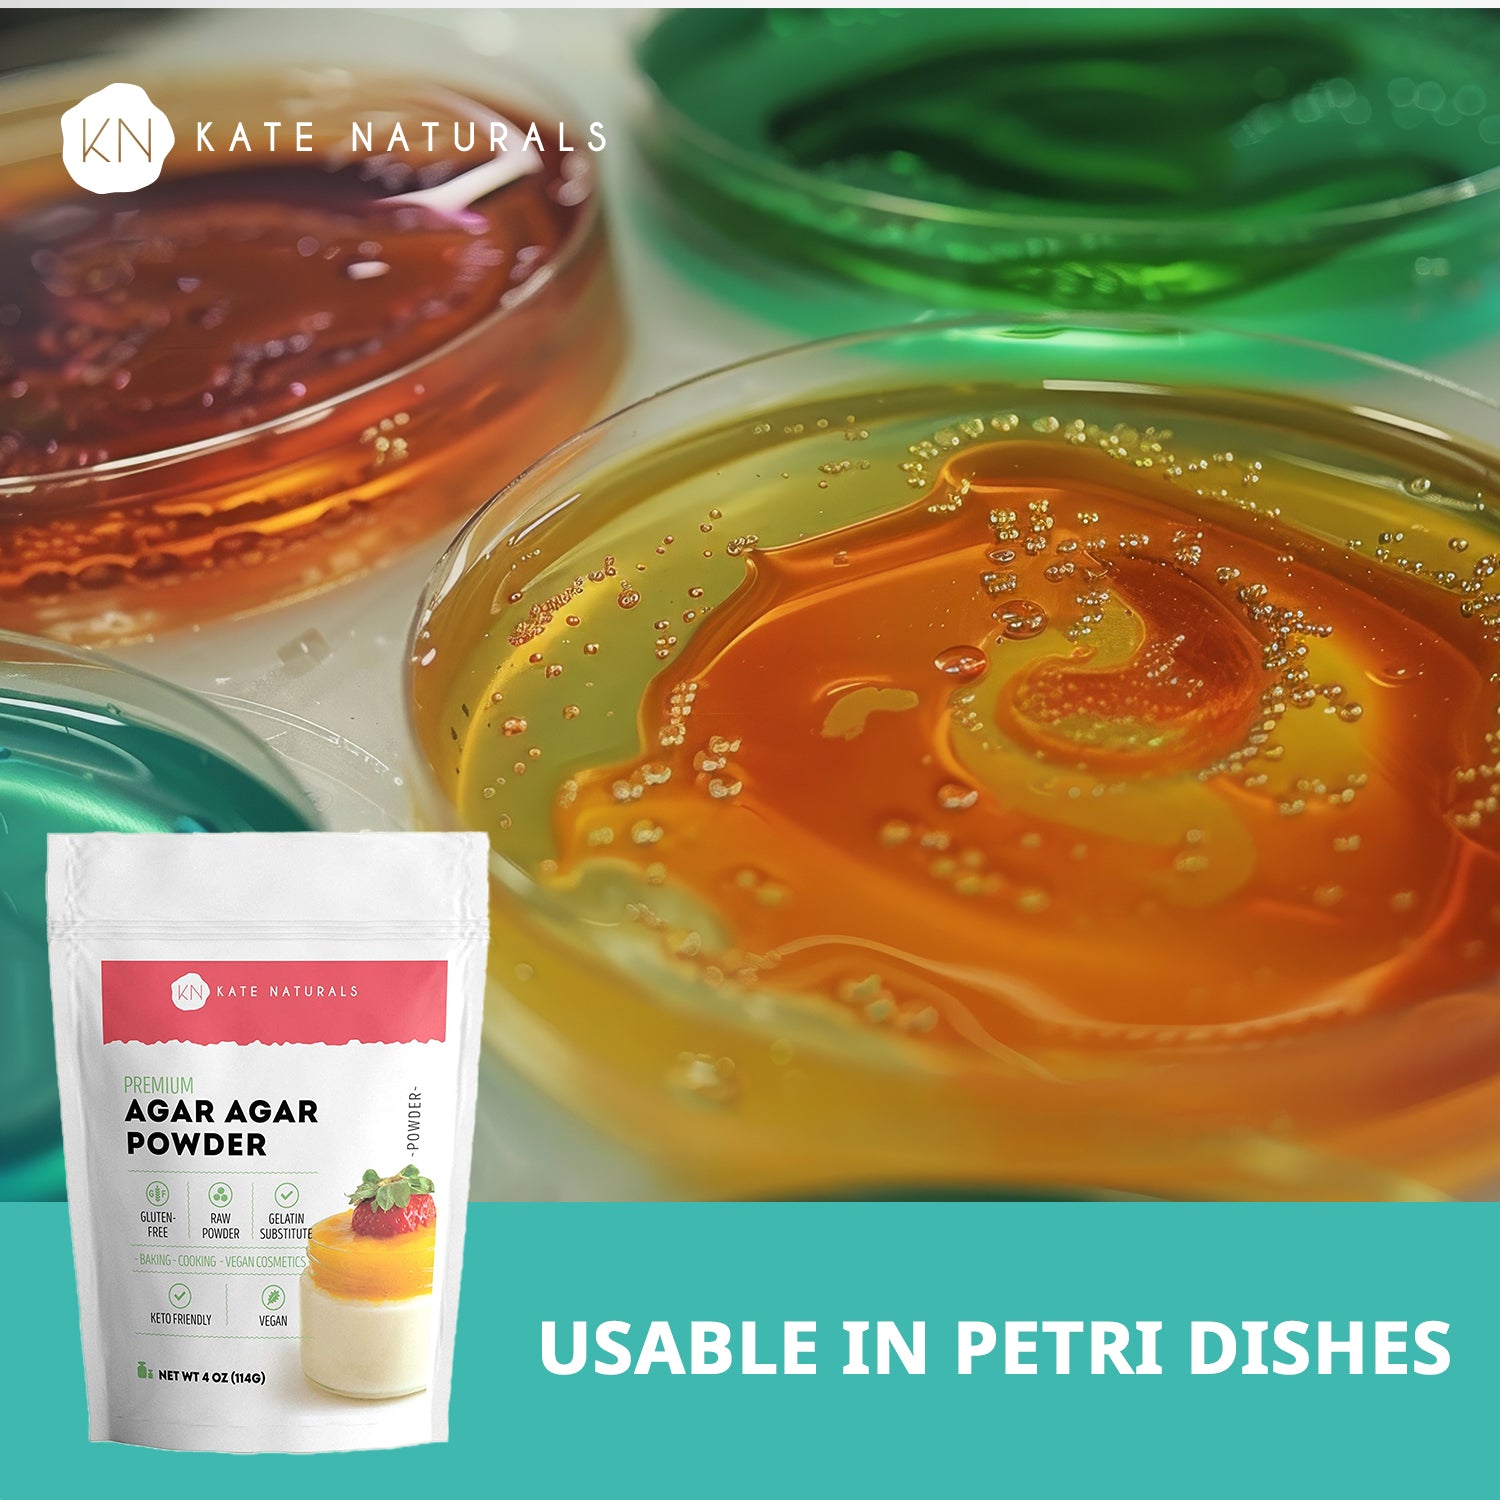

Kate Naturals
Agar Agar Powder
Agar Agar Powder
Couldn't load pickup availability
THICKENING AGENT: Agar agar powder is a versatile thickener perfect for creamy soups, jellies, ice creams, candies, and gelatin recipes. It’s a popular ingredient for vegan cheese and a plant-based gelling agent that strengthens and stabilizes desserts. No odor.
AGAR AGAR FOR WINE JELLY & BAKING: Agar-Agar Powder is ideal for making wine jelly, vegan jello mix, baking cakes, cupcakes, and desserts. This plant-based gelatin alternative can also be used to make plant based cheese.
NATURAL SOURCE OF NUTRIENTS: Agar agar powder is a plant-based ingredient that is naturally a source of fiber and trace minerals, making it a useful ingredient for those following plant-based diets. It’s an easy addition to smoothies, baked goods, and other recipes.
VEGAN & KETO-FRIENDLY: Derived from seaweed, agar agar is naturally free from sugar and carbs, making it a popular choice for vegan and keto-friendly recipes. Its smooth gelling properties make it ideal for plant-based cooking and low-carb desserts.
QUALITY GUARANTEE: We know you’ll love our healthy and natural Agar Agar powder but if you are not completely satisfied, let us know and we’ll make it right.
WARNING: Lead is known to the State of California to cause cancer and reproductive harm. www.P65Warnings.ca.gov
FAQs at www.KateNaturals.com/P65
Share